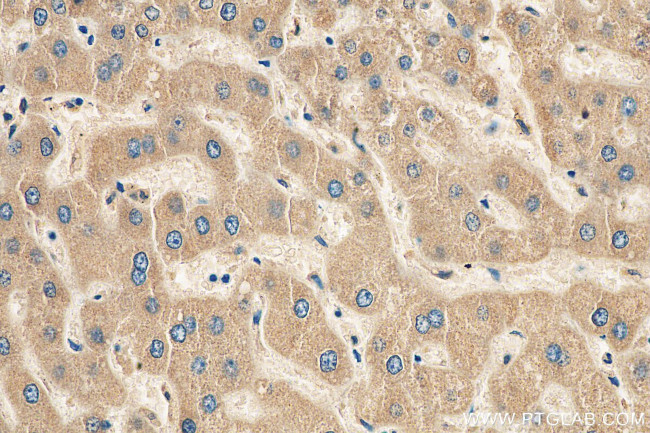
APOC3 Antibody in Immunohistochemistry (Paraffin) (IHC (P))

Search
Proteintech
APOC3 Polyclonal Antibody
{{$productOrderCtrl.translations['antibody.pdp.commerceCard.promotion.promotions']}}
{{$productOrderCtrl.translations['antibody.pdp.commerceCard.promotion.viewpromo']}}
{{$productOrderCtrl.translations['antibody.pdp.commerceCard.promotion.promocode']}}: {{promo.promoCode}} {{promo.promoTitle}} {{promo.promoDescription}}. {{$productOrderCtrl.translations['antibody.pdp.commerceCard.promotion.learnmore']}}
产品信息
22262-1-AP
种属反应
已发表种属
宿主/亚型
分类
类型
抗原
偶联物
形式
浓度
规格
纯化类型
保存液
内含物
保存条件
运输条件
靶标信息
Apolipoprotein C-III, also known as apo-CIII, is a protein that in humans is encoded by the APOC3 gene. Apo-CIII is a component of very low density lipoprotein (VLDL). APOC3 inhibits lipoprotein lipase and hepatic lipase; it is thought to delay catabolism of triglyceride-rich particles. The APOA1, APOC3 and APOA4 genes are closely linked in both rat and human genomes. The A-I and A-IV genes are transcribed from the same strand, while the A-1 and C-III genes are convergently transcribed. An increase in apoC-III levels induces the development of hypertriglyceridemia.
仅用于科研。不用于诊断过程。未经明确授权不得转售。
生物信息学
蛋白别名: Apo-CIII; Apolipoprotein; Apolipoprotein C-III; apolipoprotein C-III precursor; Apolipoprotein C3; MGC150353; unnamed protein product
基因别名: Apo-C3; ApoC-3; APOC3; APOCIII
UniProt ID: (Human) P02656
Entrez Gene ID: (Human) 345